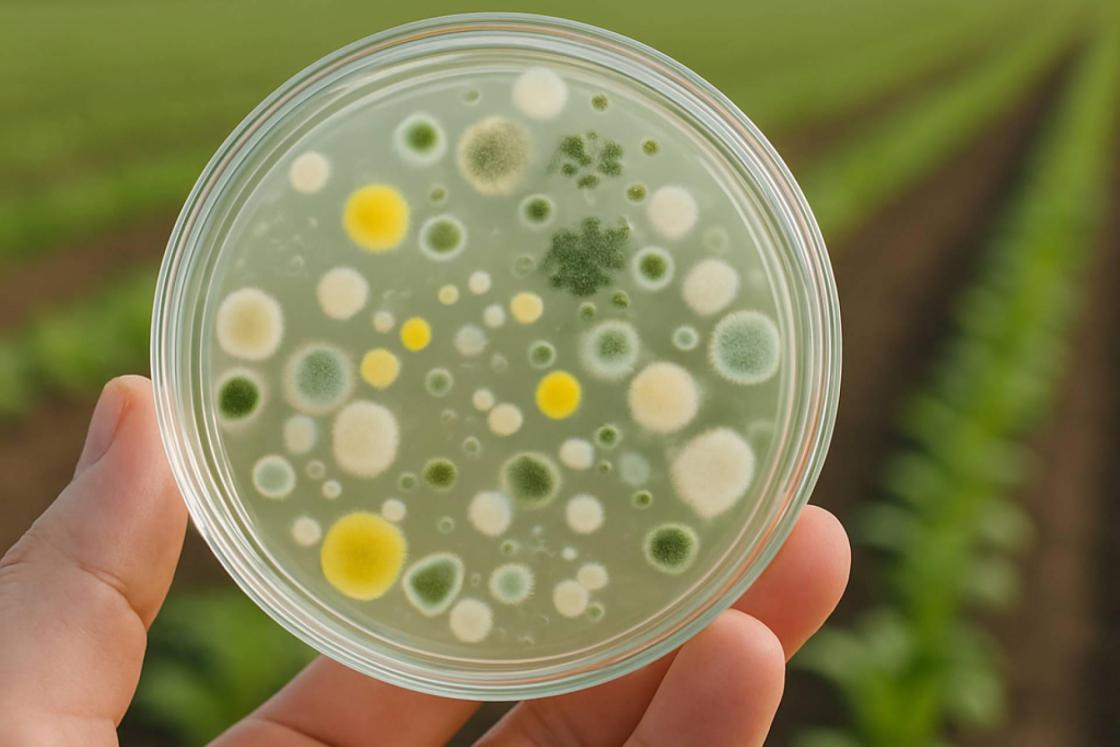
Cómo ciertas bacterias contribuyen a proteger cosechas y a mejorar la calidad de los alimentos

(Información remitida por la entidad que la firma:)
Parece ciencia ficción, pero es agricultura del siglo XXI. En los últimos años, miles de agricultores en España están incorporando microorganismos “buenos” a sus cultivos. Se trata de bacterias y hongos que no solo no dañan el suelo, sino que lo regeneran, lo enriquecen y ayudan a que las plantas crezcan más fuertes, con menos necesidad de productos químicos agresivos.
Y lo más curioso es que estos microorganismos ya estaban ahí desde siempre… solo que ahora saben cómo utilizarlos mejor.
¿Bacterias en el campo? Así funciona esta revolución silenciosa
Durante décadas, la agricultura ha dependido en gran parte de fertilizantes y productos químicos para aumentar la producción. Y aunque estos métodos han sido eficaces, también han provocado un desgaste en los suelos, una pérdida de biodiversidad y un aumento de residuos y emisiones.
¿La alternativa? Volver a mirar hacia la naturaleza.
Científicos de todo el mundo —y también en España— han redescubierto el poder de las bacterias y los hongos beneficiosos del suelo: pequeños organismos vivos que pueden:
Fijar nitrógeno del aire (como hacen las leguminosas)
Ayudar a las raíces a absorber mejor el fósforo y el potasio
Proteger a las plantas de enfermedades al activar sus defensas naturales
Mejorar la estructura del suelo y mantener la humedad
En otras palabras: trabajan con la planta, no contra ella.
Lo que no se ve… también alimenta
Este tipo de microorganismos actúan como probióticos del suelo. Al igual que se toman yogures con bífidus para mejorar la salud intestinal, estos biofertilizantes vivos ayudan a que el suelo esté más equilibrado, lleno de vida útil, y con capacidad para alimentar mejor a las plantas.
Los resultados ya se están viendo en cultivos de todo el país: mejores rendimientos, plantas más sanas y suelos más vivos.
Y lo mejor: sin residuos químicos y con un impacto mucho menor en el medioambiente.
Una empresa española al frente de este cambio
En este contexto, una empresa española está llamando la atención por su enfoque científico y su compromiso con una agricultura más respetuosa: Nostoc Biotech.
Con sede en Almería, Nostoc desarrolla biofertilizantes vivos basados en cepas de bacterias y hongos registradas oficialmente por el Ministerio de Agricultura. No se trata de mezclas sin control: son productos seguros, eficaces y autorizados, que ya están utilizando agricultores de toda España.
Desde bacterias que mejoran la absorción de nutrientes hasta hongos que activan las defensas de la planta, sus soluciones están pensadas para regenerar el suelo desde dentro.
¿Y esto se puede comprar?
Sí. Aunque suene muy técnico, estos productos ya están disponibles en el mercado, y no solo para grandes explotaciones. A través de su web, Nostoc ofrece asesoramiento y venta directa para todo tipo de agricultores, desde profesionales hasta pequeñas fincas familiares que quieren dar un paso hacia una agricultura más natural.
El dato que resume todo esto
Un solo gramo de suelo sano puede contener más de mil millones de bacterias beneficiosas.
Hoy, por fin, se sabe cómo ponerlas a trabajar para mejorar nuestros cultivos… y también lo que se come.
Si se quiere saber más sobre cómo estos microorganismos están cambiando la forma de cultivar en España, se puede visitar: www.nostoc.es
DATOS PÚBLICOS:
(Información remitida por la empresa firmante)
IMAGEN: Nostoc Biotech
PIE DE FOTO: Cómo ciertas bacterias contribuyen a proteger cosechas y a mejorar la calidad de los alimentos
Contacto Emisor: Nostoc Biotech Contacto: Nostoc Biotech Número de contacto: 644347003
AGENCIA EFE S.A.U.,S.M.E. no se hace responsable de la información que contiene este mensaje y no asume responsabilidad alguna frente a terceros sobre su íntegro contenido, quedando igualmente exonerada de la responsabilidad de la entidad autora de este. Agencia EFE se reserva el derecho a distribuir el comunicado de prensa dentro de la línea informativa, o bien a publicarlo en EFE Comunica.